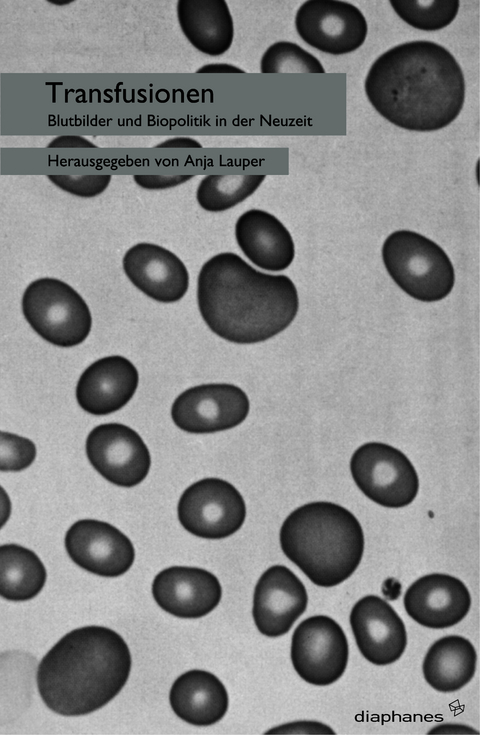
Transfusionen -

Transfusionen
Seit der frühen Neuzeit erfuhr die Rede vom Blut wiederholte Umcodierungen: transformiert sich das christliche Blut des Erlösers nach 1600 zum physiologischen Träger des Lebens, so markiert 1800 das historische Datum, an dem es vom sozialen Unterscheidungsmerkmal zum Objekt eines Wissens vom Leben avanciert. Im Dispositiv der Bio-Politik wird das Blut zum Lebenssaft des biologischen wie des politischen Körpers.
Der Diskurs des Blutes wird von den verschiedensten Medien produziert, in Umlauf gebracht und reguliert, oder aber er wird selbst zum Medium. Die Momente des Übergangs, die Transfusionen zwischen verschiedenen Wissenskreisläufen, zwischen Kunst und Literatur, Ökonomie und Lebenswissenschaften sind das Thema des vorliegenden Bandes.
Anja Lauper war wissenschaftliche Mitarbeiterin der Forschergruppe »Das Leben schreiben« an der Fakultät Medien der Bauhaus-Universität Weimar sowie des Graduiertenkollegs »Codierung von Gewalt im medialen Wandel« an der Humboldt-Universität zu Berlin. Sie lebt und arbeitet als Literaturwissenschaftlerin in Zürich.
7 - 18 Einleitung (Anja Lauper)21 - 49 Blut der Bilder (Georges Didi-Huberman)51 - 70 Blutiger Mord (Anne von der Heiden)71 - 83 Dünne rote Linie (Claudia Blümle)85 - 96 Blutgenuss und Bilderfluten (Frank Hiddemann)99 - 117 Kreisläufe (Joseph Vogl)119 - 138 Blut sehen (Karin Leonhard)139 - 155 »Der Lebensproceß im Blute« (Anja Lauper)157 - 177 »Gute Nacht du liebes Blut« (Gabriele Brandstetter)179 - 196 »Der Blutkreislauf der Familie« (Gerhard Neumann)199 - 210 Im Proletformat (Margarete Vöhringer)211 - 225 »Reines« und »gemischtes Blut« (Myriam Spörri)227 - 241 Blutspuren (Jörg Wiesel)243 - 266 »Ich kann beim besten Willen kein Blut sehen« (Ute Holl)267 Die Autoren269 - 272 Namenindex273 - 288 Bildteil
| Erscheint lt. Verlag | 1.6.2005 |
|---|---|
| Reihe/Serie | sequenzia |
| Zusatzinfo | 16 farb. Abb. |
| Verlagsort | Zürich-Berlin |
| Sprache | deutsch |
| Maße | 153 x 233 mm |
| Gewicht | 505 g |
| Themenwelt | Kunst / Musik / Theater ► Kunstgeschichte / Kunststile |
| Geisteswissenschaften | |
| Studium ► Querschnittsbereiche ► Geschichte / Ethik der Medizin | |
| Sozialwissenschaften | |
| Schlagworte | Biopolitik • Blut • Blut (Motiv) • Hardcover, Softcover / Geisteswissenschaften allgemein • HC/Geisteswissenschaften allgemein • Körper • Kulturwissenschaft • Kunstwissenschaften • Lebenswissenschaft • Maltechniken • Mediengeschichte • Medienwissenschaft • Medizin • Medizingeschichte • Religion • Ritual • Symbolik • Vampirismus • Wissenschaftsgeschichte • Zirkulation |
| ISBN-10 | 3-935300-53-0 / 3935300530 |
| ISBN-13 | 978-3-935300-53-7 / 9783935300537 |
| Zustand | Neuware |
| Informationen gemäß Produktsicherheitsverordnung (GPSR) | |
| Haben Sie eine Frage zum Produkt? |
aus dem Bereich